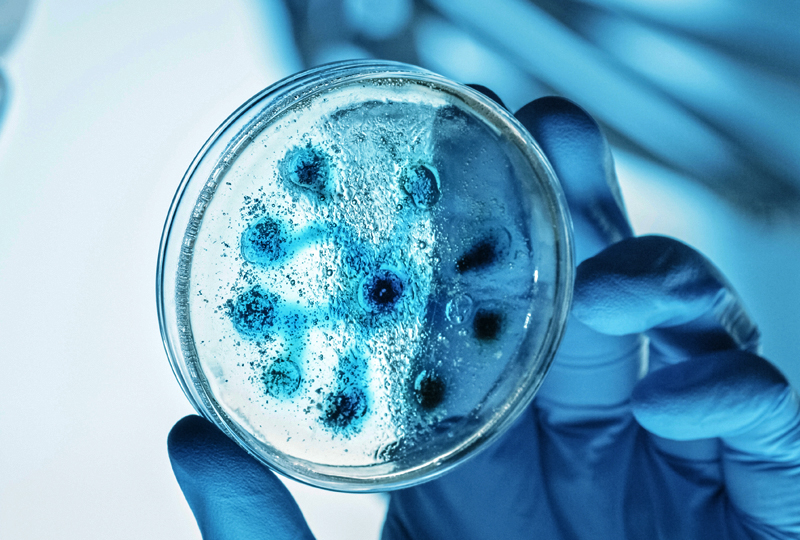

ABOUTGEM Biosciences
맞춤형 마우스 제작부터 비임상 연구까지, 젬바이오사이언스㈜는 마우스 기반 CRO 전문 기업 입니다. 정확한 실험과 책임 있는 결과를 제공합니다.
실험 설계부터 데이터 분석까지, 젬바이오사이언스는 연구자의 든든한 실험 파트너입니다. 전 과정 맞춤형 지원으로 함께 성장합니다.
정확한 실험, 신뢰할 수 있는 데이터. 젬바이오사이언스㈜는 인간화 마우스 기반의 비임상 CRO 전문기업입니다. 맞춤형 실험동물 제작부터 면역세포 분석, 약효 검증까지전 과정을 원스톱으로 지원합니다.


CONTACT
-

- info@gembio.co.kr
-

- Phone
- 043-267-0717
-

Online Inquiry
바로가기